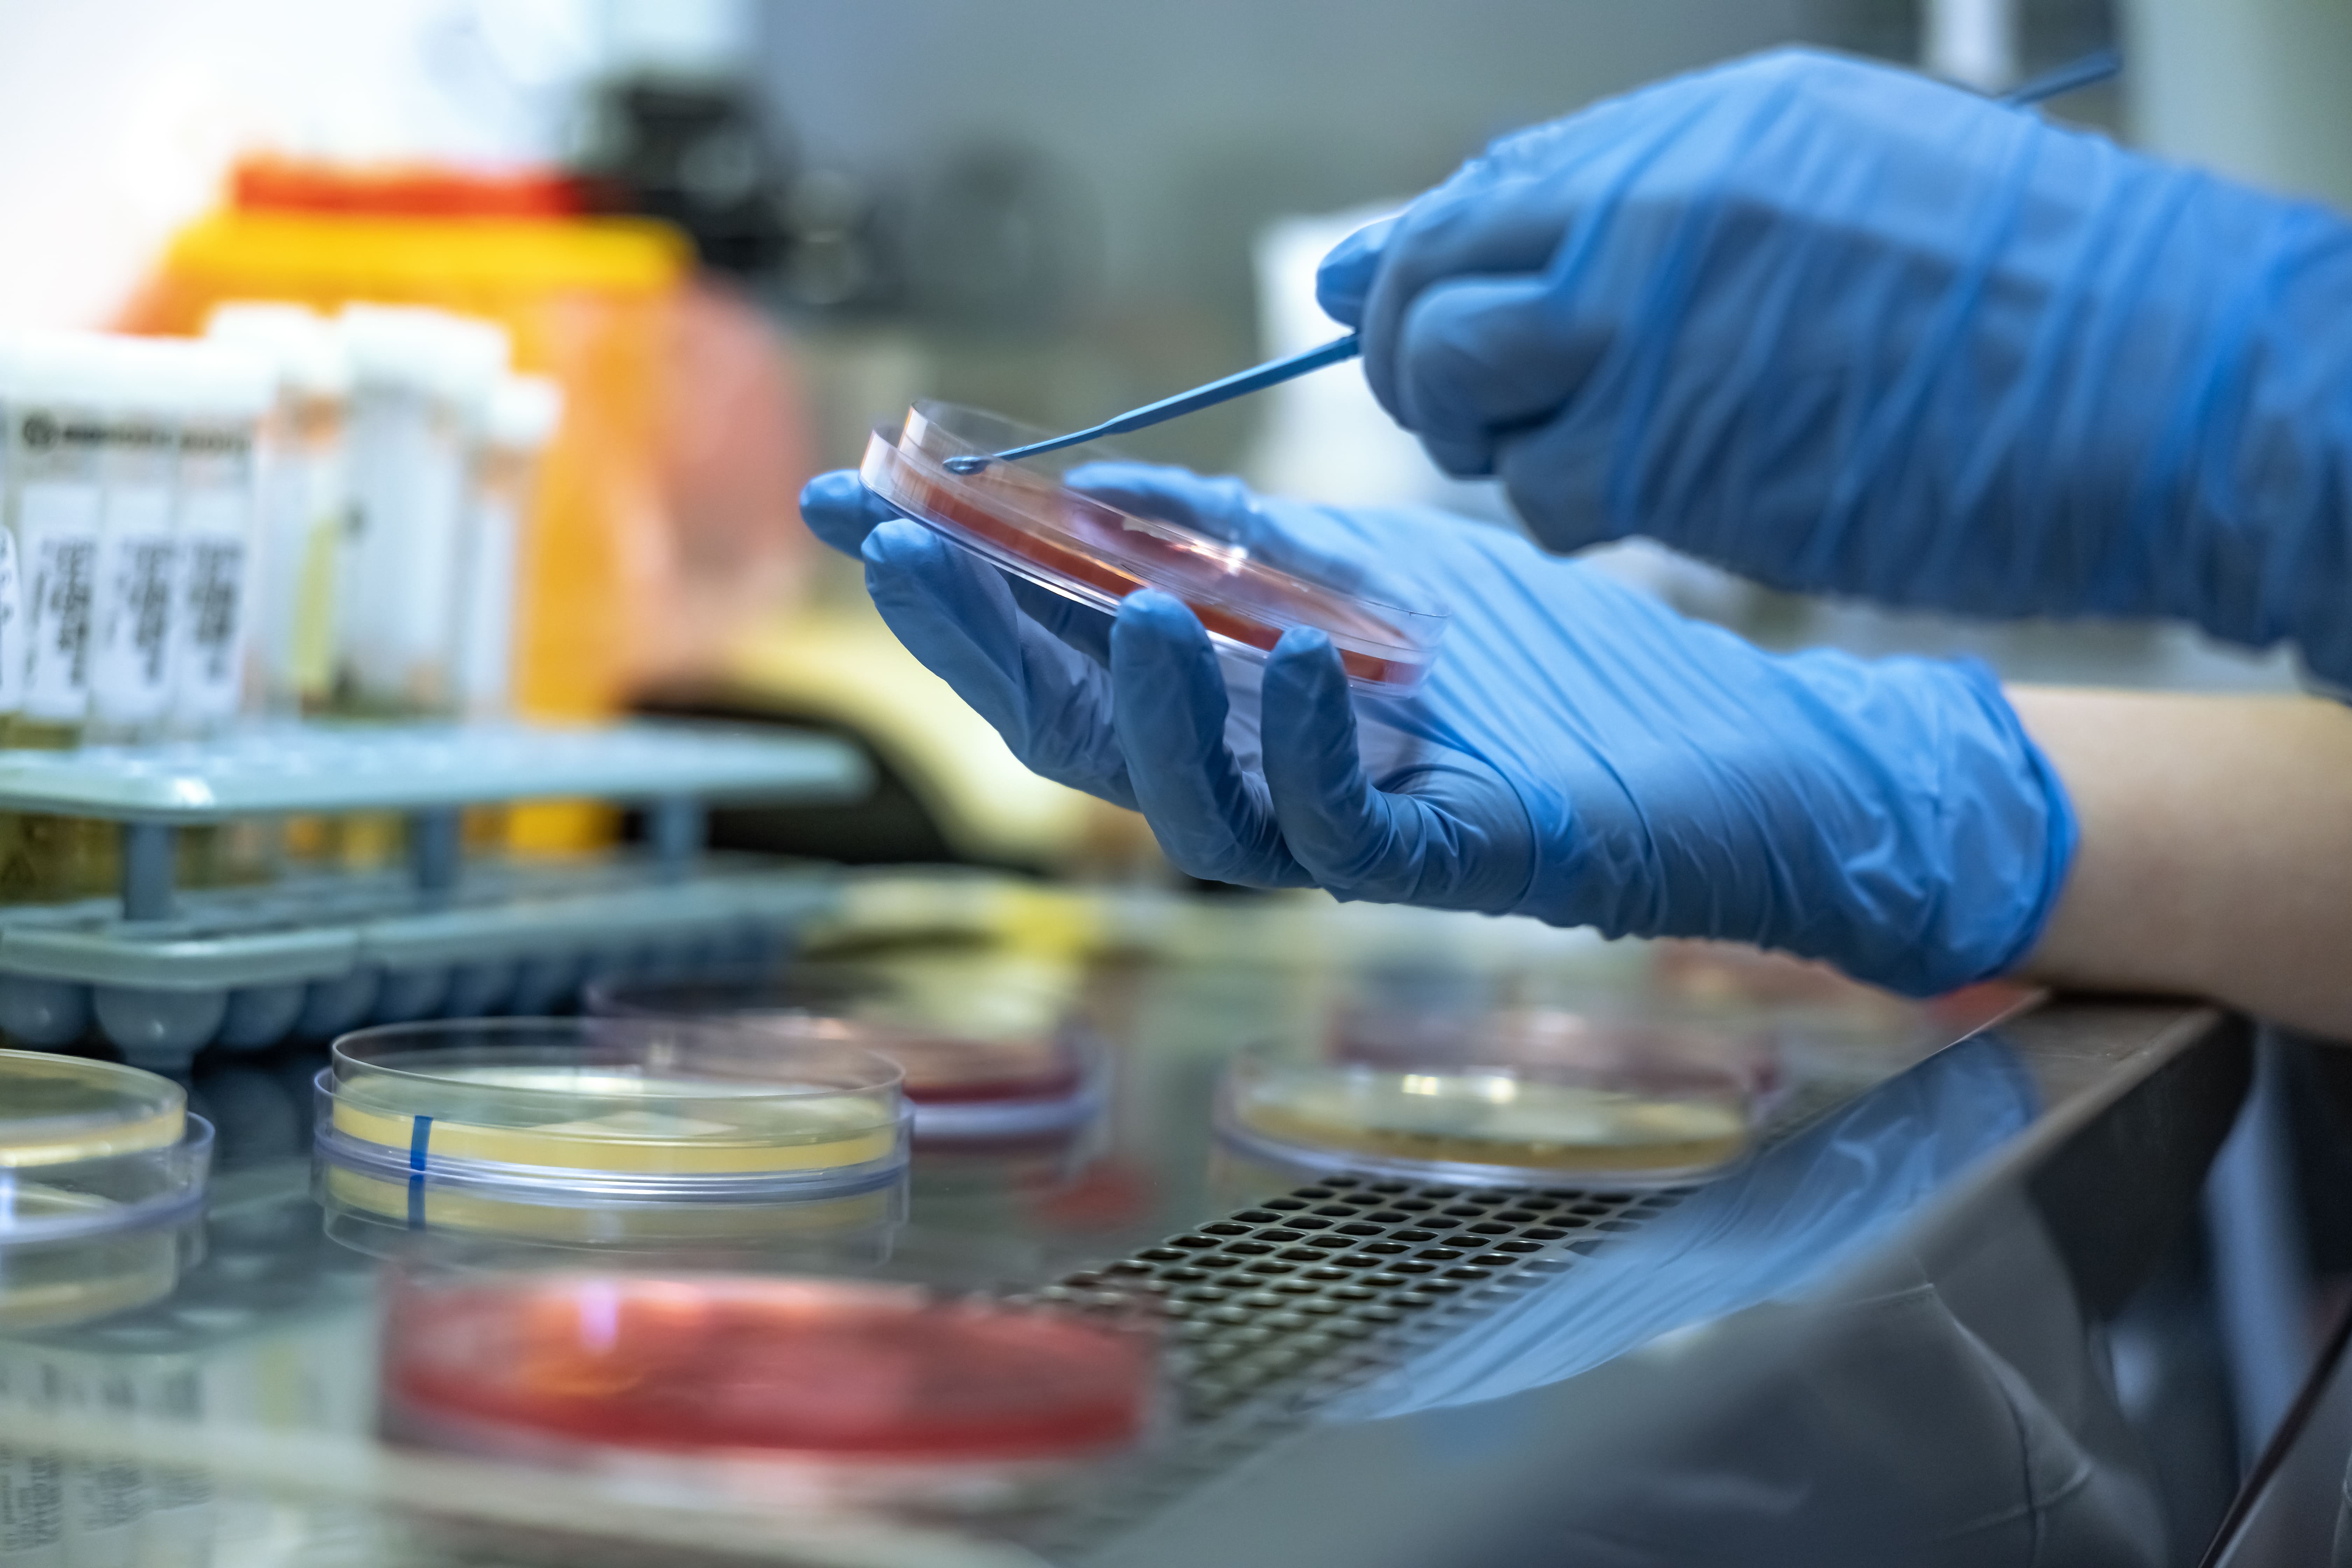
Lab Photo

Мобил Медикал Лаб
для корпоративных клиентов
Надёжное
партнёрство
Операционная
эффективность
Обширная
география
Виртуальная экскурсия по лаборатории
Почему выбирают ММЛ
Инвестиции в технологии, влияющие на скорость, качество и стоимость диагностики, а не в маркетинг и административные расходы позволяют обеспечить:
Передовые технологии
Максимальная автоматизация и цифровизация. Собственные инновационные разработки
Скорость
Оптимальное расположение в центре Москвы, передовое оборудование. Срок выдачи потоковых тестов — в часах
Стабильное качество
Внутренний и внешний контроль качества (российский и международный). Управление качеством согласно ГОСТ Р ИСО 9001:2024
Честная цена
Конкурентная цена без наценки за бренд. Сокращение издержек за счёт оптимизации процессов
Персонализированный подход
Формат ММЛ позволяет гибко подстраивать технологические процессы под динамически меняющиеся условия рынка и потребности клиента.
Только факты
Клиенты растут вместе с лабораторией
За время совместной работы — от небольшой клиники до многопрофильных центров
Отлаженная логистика
Доставка биоматериала из всех регионов России от Калининграда до Челябинска, от Ханты-Мансийска до Владикавказа
Многопрофильная лаборатория
Технологическая площадка в центре Москвы с удобным расположением, оснащенная современным оборудованием
Технологичность = скорость
Топовые исследования выполняются за 2-4 часа от момента доставки пробы в лабораторию
Гарантированное качество
Сертификация с 2016 года по стандартам ИСО 9001, с ежегодным аудитом и ресертификацией
Гибкие правила преаналитики
Адаптация процессов подготовки и обработки биоматериала под требования каждого партнёра
Главное преимущество лаборатории — команда профессионалов
Большинство ключевых специалистов работает с основания лаборатории. Руководство компании уделяет большое внимание регулярному повышению квалификации персонала.
Преемственность
Опыт и знания передаются внутри команды, обеспечивая стабильность процессов
Точность
Высокая квалификация каждого специалиста гарантирует безошибочную работу
Уверенность
Стабильное качество на каждом этапе диагностики и обслуживания
Экспертиза в каждой области
Каждый член команды — эксперт в своей области, способный решать нестандартные задачи и обеспечивать качество на всех этапах диагностики.
Устойчивое партнерство
Многие клиенты продолжают партнерские отношения с лабораторией в течение многих лет. Доверие формируется за счёт аккуратной работы, честных цен и уважения к партнёру.
Запросить коммерческое предложениеОтвет специалиста — в течение 24 часов в рабочее время